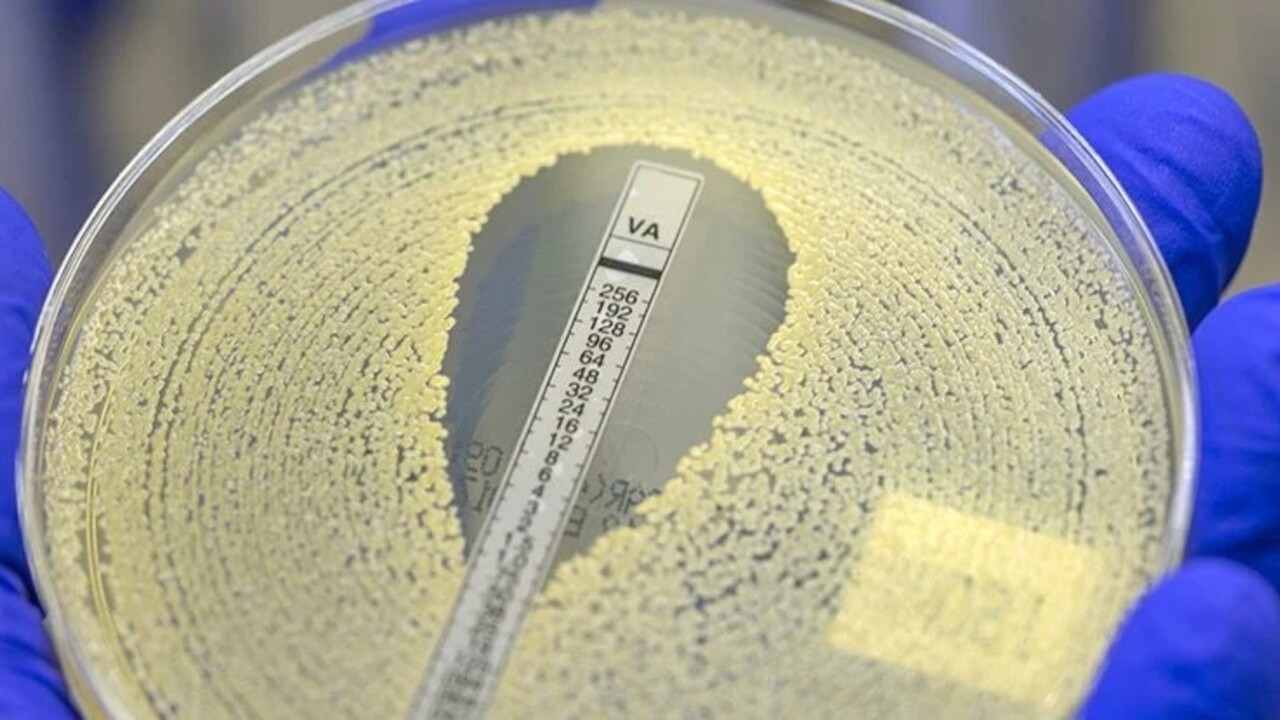
78a59f8b45906343071619a73229d541c78eff32

Сколько людей умерли за год из-за злоупотребления антибиотиками
Отмечается, что исследование затронуло 2019 год, с которого начала расти смертность от развития устойчивых к противомикробным средствам бактериальных инфекций. Учёные создали статистические модели на основе изученных данных о 23 видах бактерий и 88 патогенных комбинациях, из-за которых в 2019 году скончалось 4,95 млн человек. Эти люди умерли не от отравления антибиотиками, а от бактерий, на которые перестали действовать препараты.
На эту тему уже проводились исследования, в результате которых прогнозировался рост смертности от устойчивых к антибиотикам инфекций. Предположительно, с 2050 года число смертей может составить порядка 10 млн человек в год.
Но новые данные говорят о том, что эта проблема наступит раньше. Неслучайно учёные назвали смертность от устойчивых к антибиотикам бактерий в 2019 году третьей по численности причиной смертности в мире. Только инсульт и болезни сердца забрали больше жизней.
Материалы новостного характера нельзя приравнивать к назначению врача. Перед принятием решения посоветуйтесь со специалистом.
© Ferra.ru
